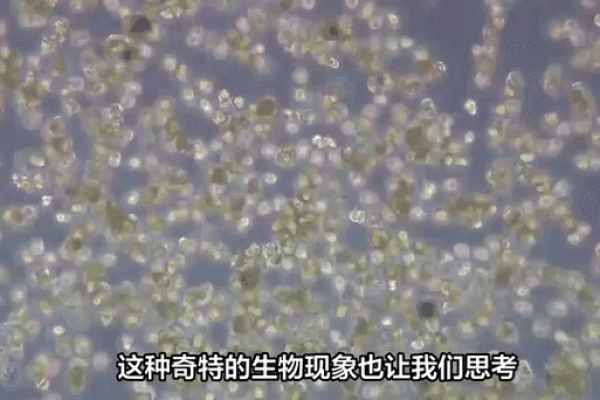
生命的神秘：揭示生物六大生命现象的奥秘

生命的神秘:揭示生物六大生命现象的奥秘
- 查询吧
- 2025-01-04 05:00:01
生物的生命现象是自然界中最为奇妙的存在之一。无论是单细胞微生物,还是复杂的人类,每一种生物都展现出独特的生命特征。今天,我们将深入探讨生物的六大生命现象,带领大家了解生命的本质与奥秘。
首先,我们必须提到的是“代谢”。代谢是指生物体内发生的化学反应过程,可分为合成代谢和分解代谢。合成代谢是生物从简单的化合物中合成复杂的有机物,而分解代谢则是将复杂的有机物分解为简单的化合物,从而释放能量。生物依靠代谢过程维持生命所需的能量和物质,这一现象展示了生命的动态平衡。无论是我们日常摄取的食物,还是植物通过光合作用获得的能量,都在代谢中发挥着关键作用。
其次,生长是另一“生命现象”。生物在一定的条件下都会经历生长,从而实现体积和质量的增加。无论是幼苗到大树的转变,还是胚胎到成熟个体的发育,生长不仅仅是尺寸的变化,更是生命的进化过程。生物生长的背后,隐藏着基因的活动、环境的影响以及营养的供应。通过对生长现象的理解,我们能够更好地探索生物如何与外界环境互动,并且适应变化。
接下来是“反应”。生物对外界环境的反应是生存的关键。无论是植物对光照的向光性,还是动物对捕食者的逃避反应,反应现象使生物能够动态地适应周围的世界。这种适应能力不仅展示了生命的灵活性,还反映了生物进化的智慧。研究生物的反应现象,我们能够理解生物如何通过感觉器官获取信息,并做出生理上的调整,以提升生存的机会。
“繁殖”是生命的延续。每一个生物体在生命周期中都会经历繁殖过程,以确保其遗传信息得以传承。繁殖可以是有性繁殖,也可以是无性繁殖,各种繁殖方式都显示出生物创造新生命的能力。有性繁殖增加了基因的多样性,而无性繁殖则能够在资源匮乏的环境中迅速扩展种群。通过繁殖现象,我们得以窥见生命的延续与进化的奥秘。
此外,生物的“适应性”也是一个迷人的生命现象。不同的生物生活在不同的生态位,其形态、行为和生理特征都随着环境的变化而变化。例如,生活在极端干旱环境中的骆驼,发展了储水的能力;而生活在寒冷地区的北极熊,则长有厚实的脂肪层以应对低温。适应性不仅影响个体的生存,也推动着整个种群的演化。这一过程让我们理解了自然选择的力量,以及物种是如何与环境协同演变的。

最后,我们不能忽视“运动”现象。运动是生物体以各种方式在空间中移动的过程。这不仅限于动物的行走、游泳和飞翔,植物的生长向日性和根系的生长也是一种运动。运动使生物体能够探索环境、寻找食物及伴侣,或逃避危险。研究运动现象的生物学家们,发现创造性地利用运动来适应环境,是生物进化的重要机制之一。
综上所述,生命的六大生命现象——代谢、生长、反应、繁殖、适应性和运动,揭示了生物体在复杂及多变的自然环境中如何运作。这些现象不仅是生物学的基础概念,更为我们提供了理解生命的视角。探究这些现象,不仅能增强我们对生命的敬畏,也能推动科学技术的发展与应用。生物的奥秘正等待着我们去进一步探索,让我们一同走入生命科学的迷人世界。